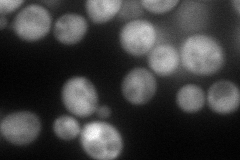
YOL077W-A
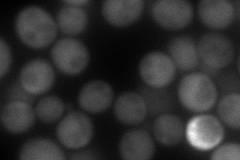
YOL077W-A
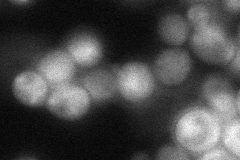
YOL077W-A
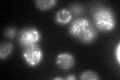
YOL077W-A
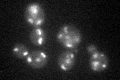
YOL077W-A
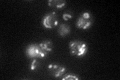
YOL077W-A

View description
Subunit k of the mitochondrial F1F0 ATP synthase, which is a large enzyme complex required for ATP synthesis; associated only with the dimeric form of ATP synthase
Localization:
Intensity:
Fold change:
Significance:
-
C’ GFP library in SD

mitochondria47.03 -
N' NOP1pr-GFP in SD
cytosol,punctate111.415 -
N' TEF2pr-mCherry in SD
cytosol106.389 -
N' NATIVEpr-GFP in SD
nucleus50.497 -
N' TEF2pr-VC and Cyto-VN in SD

#N/A0 -
C’ GFP library in SD+DTT
mitochondria34.140.72No -
C’ GFP library in SD+H2O2
mitochondria36.580.77No -
C’ GFP library in Starvation Media
mitochondria60.31.28No -
C’ GFP library on the background of Pup2-DaMP

mitochondria -
C’ GFP library on the background of CCT mutant

mitochondria36.58220.777767No
